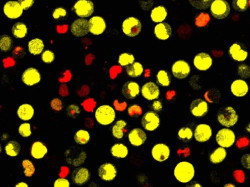
Expertos realizan un llamamiento a la supervisi&oacute;n mundial de las terapias con c&eacute;lulas madre no probadas

Las embarazadas con migraña tienen mayor riesgo de sufrir complicaciones, según una nueva investigación
Las mujeres que sufren migrañas son más propensas a sufrir complicaciones obstétricas y postnatales, según un estudio presentado este viernes en el 7º Congreso de la Academia Europea de Neurología (EAN).